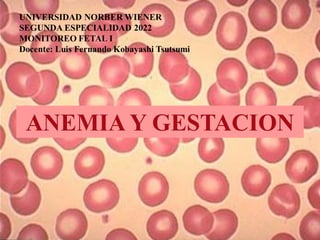

Este documento describe la anemia y los requerimientos de hierro durante el embarazo. Explica que la cantidad total de hierro requerida durante el embarazo es de 840-900 mg, lo que no puede cubrirse solo con la dieta. También describe los tipos de anemia, incluida la anemia ferropénica, y las estrategias de tratamiento y prevención, como la suplementación con hierro.